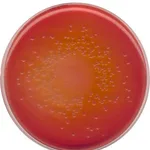
Merck MacConkey Agar

Merck Dey-Engley neutralizing broth
✨AI 추천 연관 상품
AI가 분석한 이 상품과 연관된 추천 상품들을 확인해보세요
연관 상품을 찾고 있습니다...
Dey-Engley neutralizing broth
suitable for microbiology, NutriSelect® Plus
D/E Neutralizing Broth
Quality Level
무균
non-sterile
form
powder
유통기한
limited shelf life, expiry date on the label
manufacturer/tradename
NutriSelect® Plus
technique(s)
microbiological culture: suitable
최종 pH
7.6±0.2 (25 °C)
application(s)
environmental
food and beverages
pharmaceutical
sterility testing
surface monitoring
microbiology
저장 온도
2-8°C
적합성
nonselective for Bacillus spp.
nonselective for Escherichia coli
nonselective for Pseudomonas spp.
nonselective for Salmonella spp.
nonselective for Staphylococcus spp.
nonselective for bacteria (General Media)
nonselective for coliforms
Dey-Engley Neutralizing Broth is used in disinfectant testing where the neutralization of the antiseptics and disinfectants is important for determining its bactericidal activity. The broth consists of tryptone that provides nitrogen and carbon sources, long chain amino acids, vitamins, and other essential nutrients. Dextrose is an energy source. Yeast extract is also a rich source of vitamin B-complex. Sodium bisulfite neutralizes aldehydes; sodium thioglycolate neutralizes mercurial; sodium thiosulfate neutralizes iodine and chlorine; lecithin neutralizes quaternary ammonium compounds; and polysorbate 80, a non-ionic surface-active agent, neutralizes substituted phenolics. Bromocresol purple is an indicator for dextrose utilization. Those organisms that ferment dextrose will turn the medium from purple to yellow. Growth of Pseudomonas sp., which does not ferment dextrose, can be detected by the formation of a pellicle on the surface of the broth.
배송/결제/교환/반품 안내
배송 정보
| 기본 배송비 |
| 교환/반품 배송비 |
|
|---|---|---|---|
| 착불 배송비 |
| ||
| 교환/반품 배송비 |
| ||
결제 및 환불 안내
| 결제수단 |
|
|---|---|
| 취소 |
|
| 반품 |
|
| 환급 |
|
교환 및 반품 접수
| 교환 및 반품 접수 기한 |
|
|---|---|
| 교환 및 반품 접수가 가능한 경우 |
|
| 교환 및 반품 접수가 불가능한 경우 |
|
교환 및 반품 신청
| 교환 절차 |
|
|---|---|
| 반품 절차 |
|